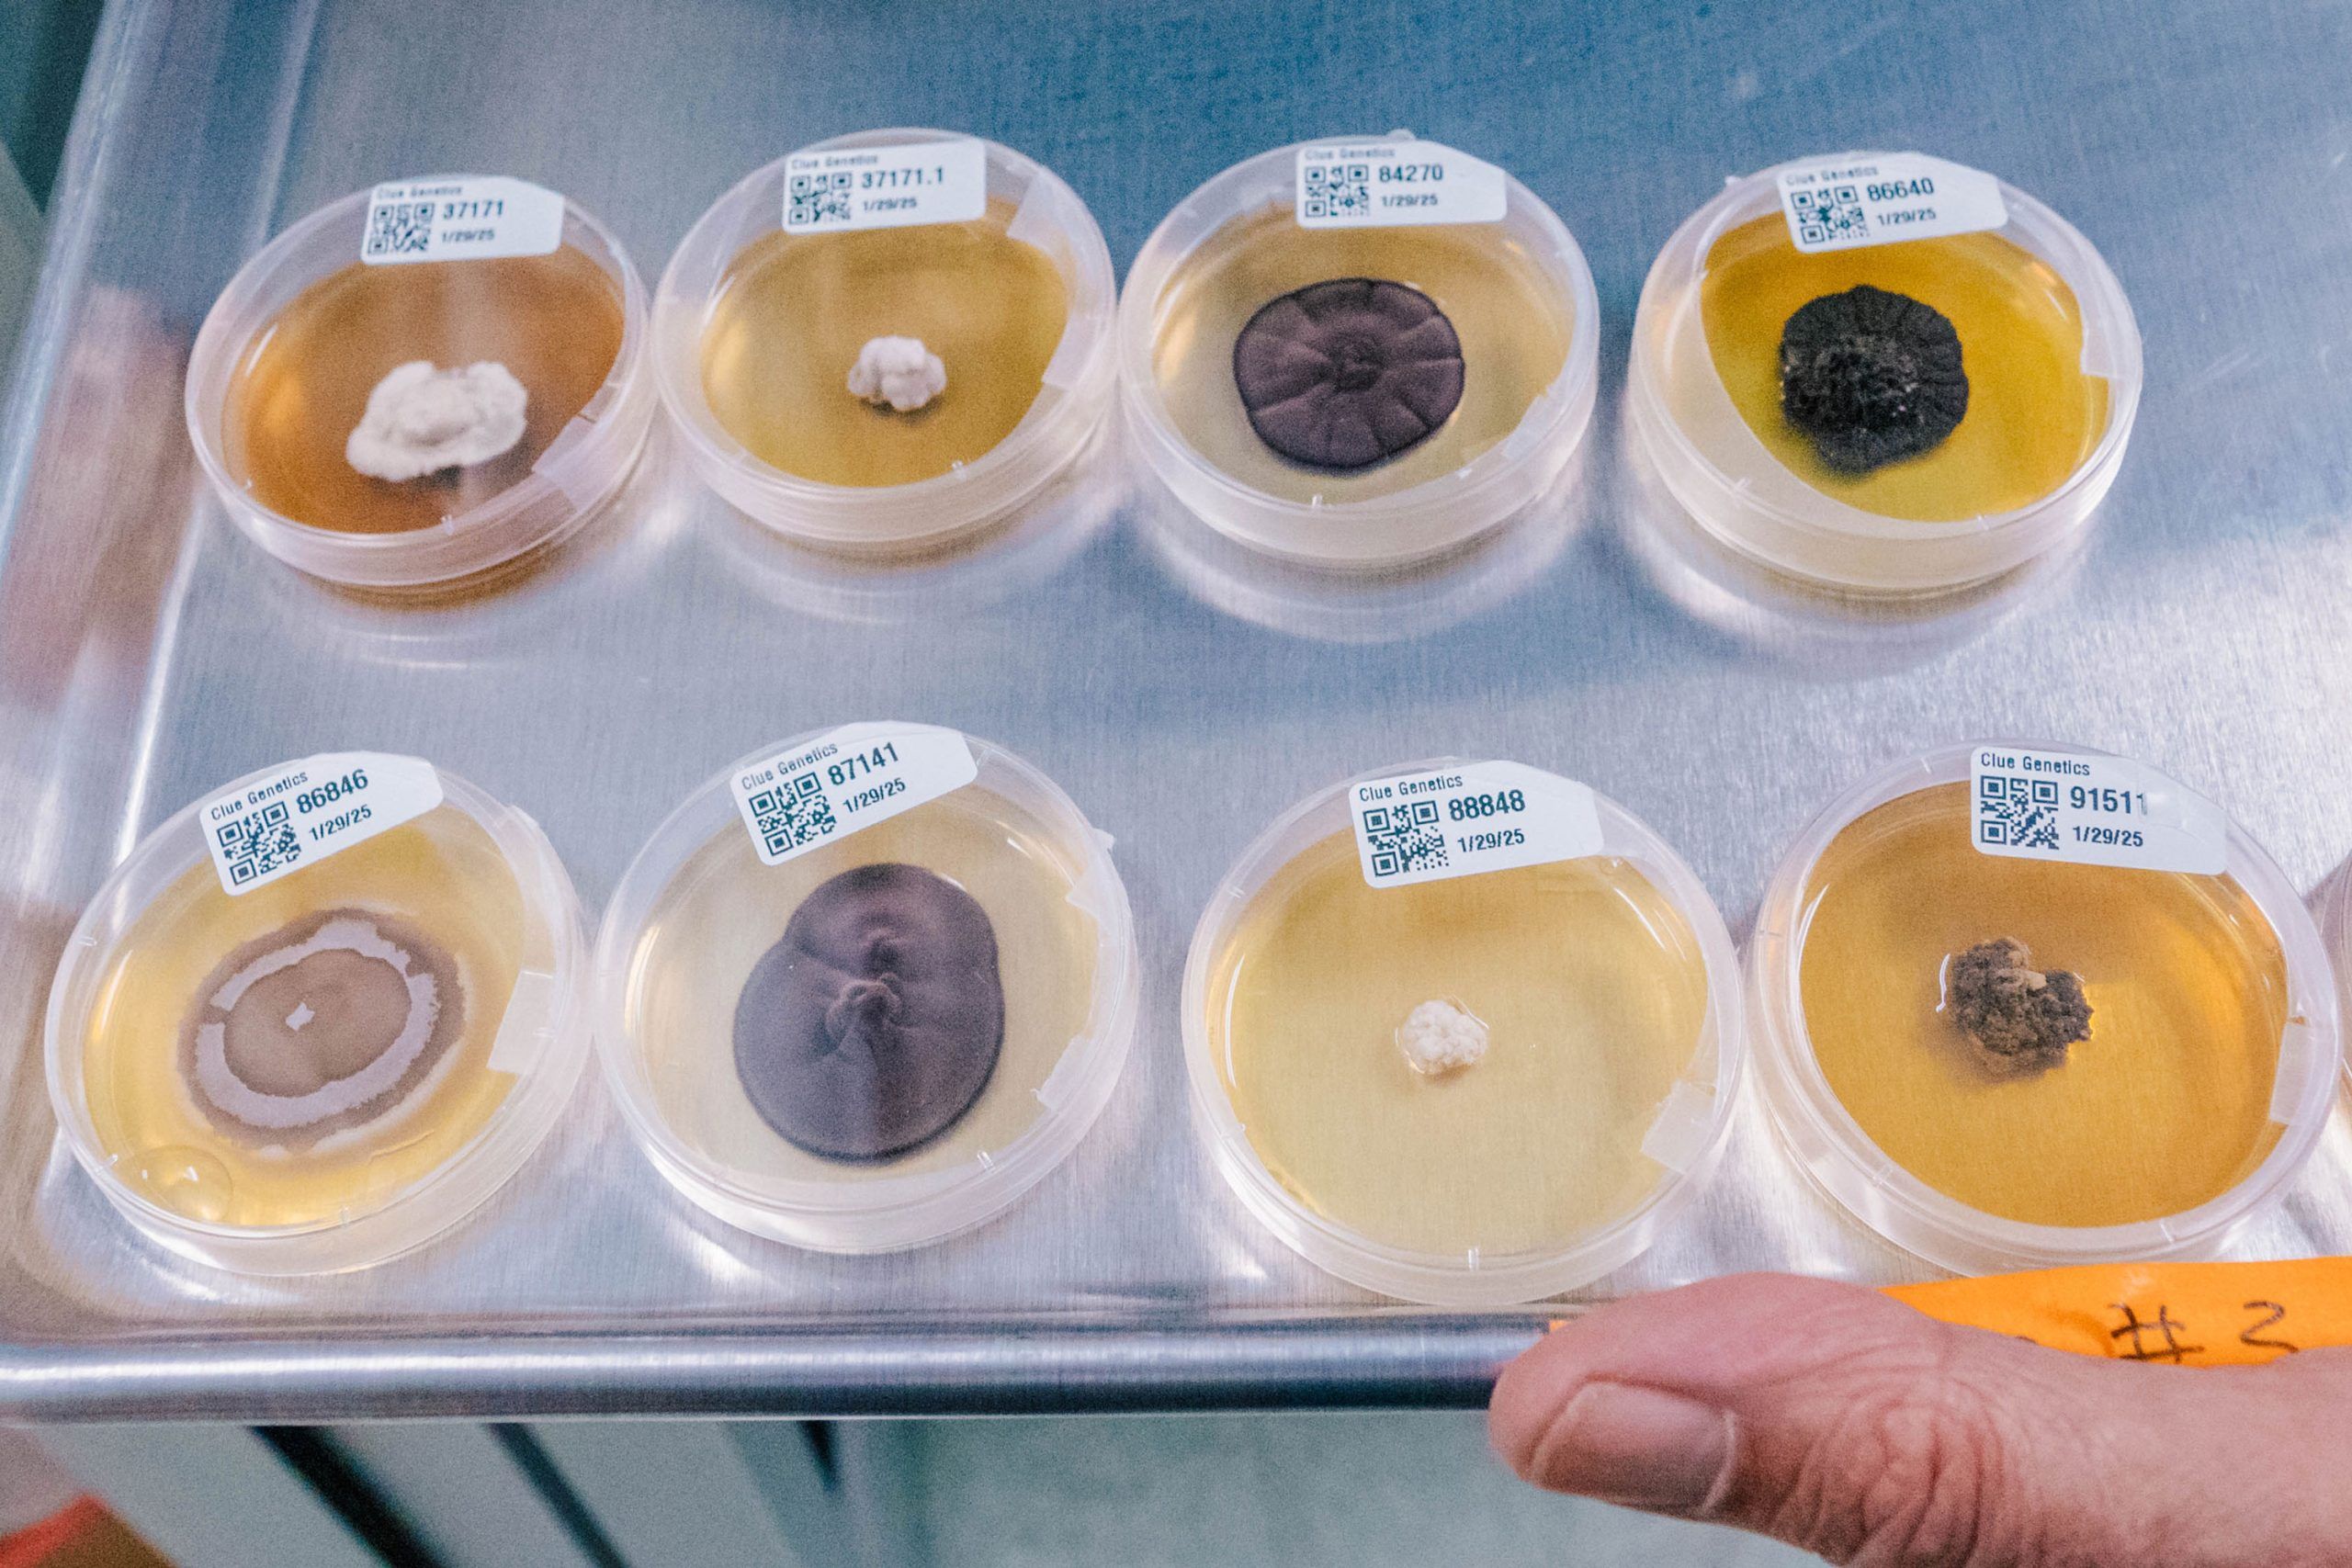
Close-up of eight clear petri dishes on a metal tray, each containing fungal cultures of varying colors and textures, with QR code labels on the lids.
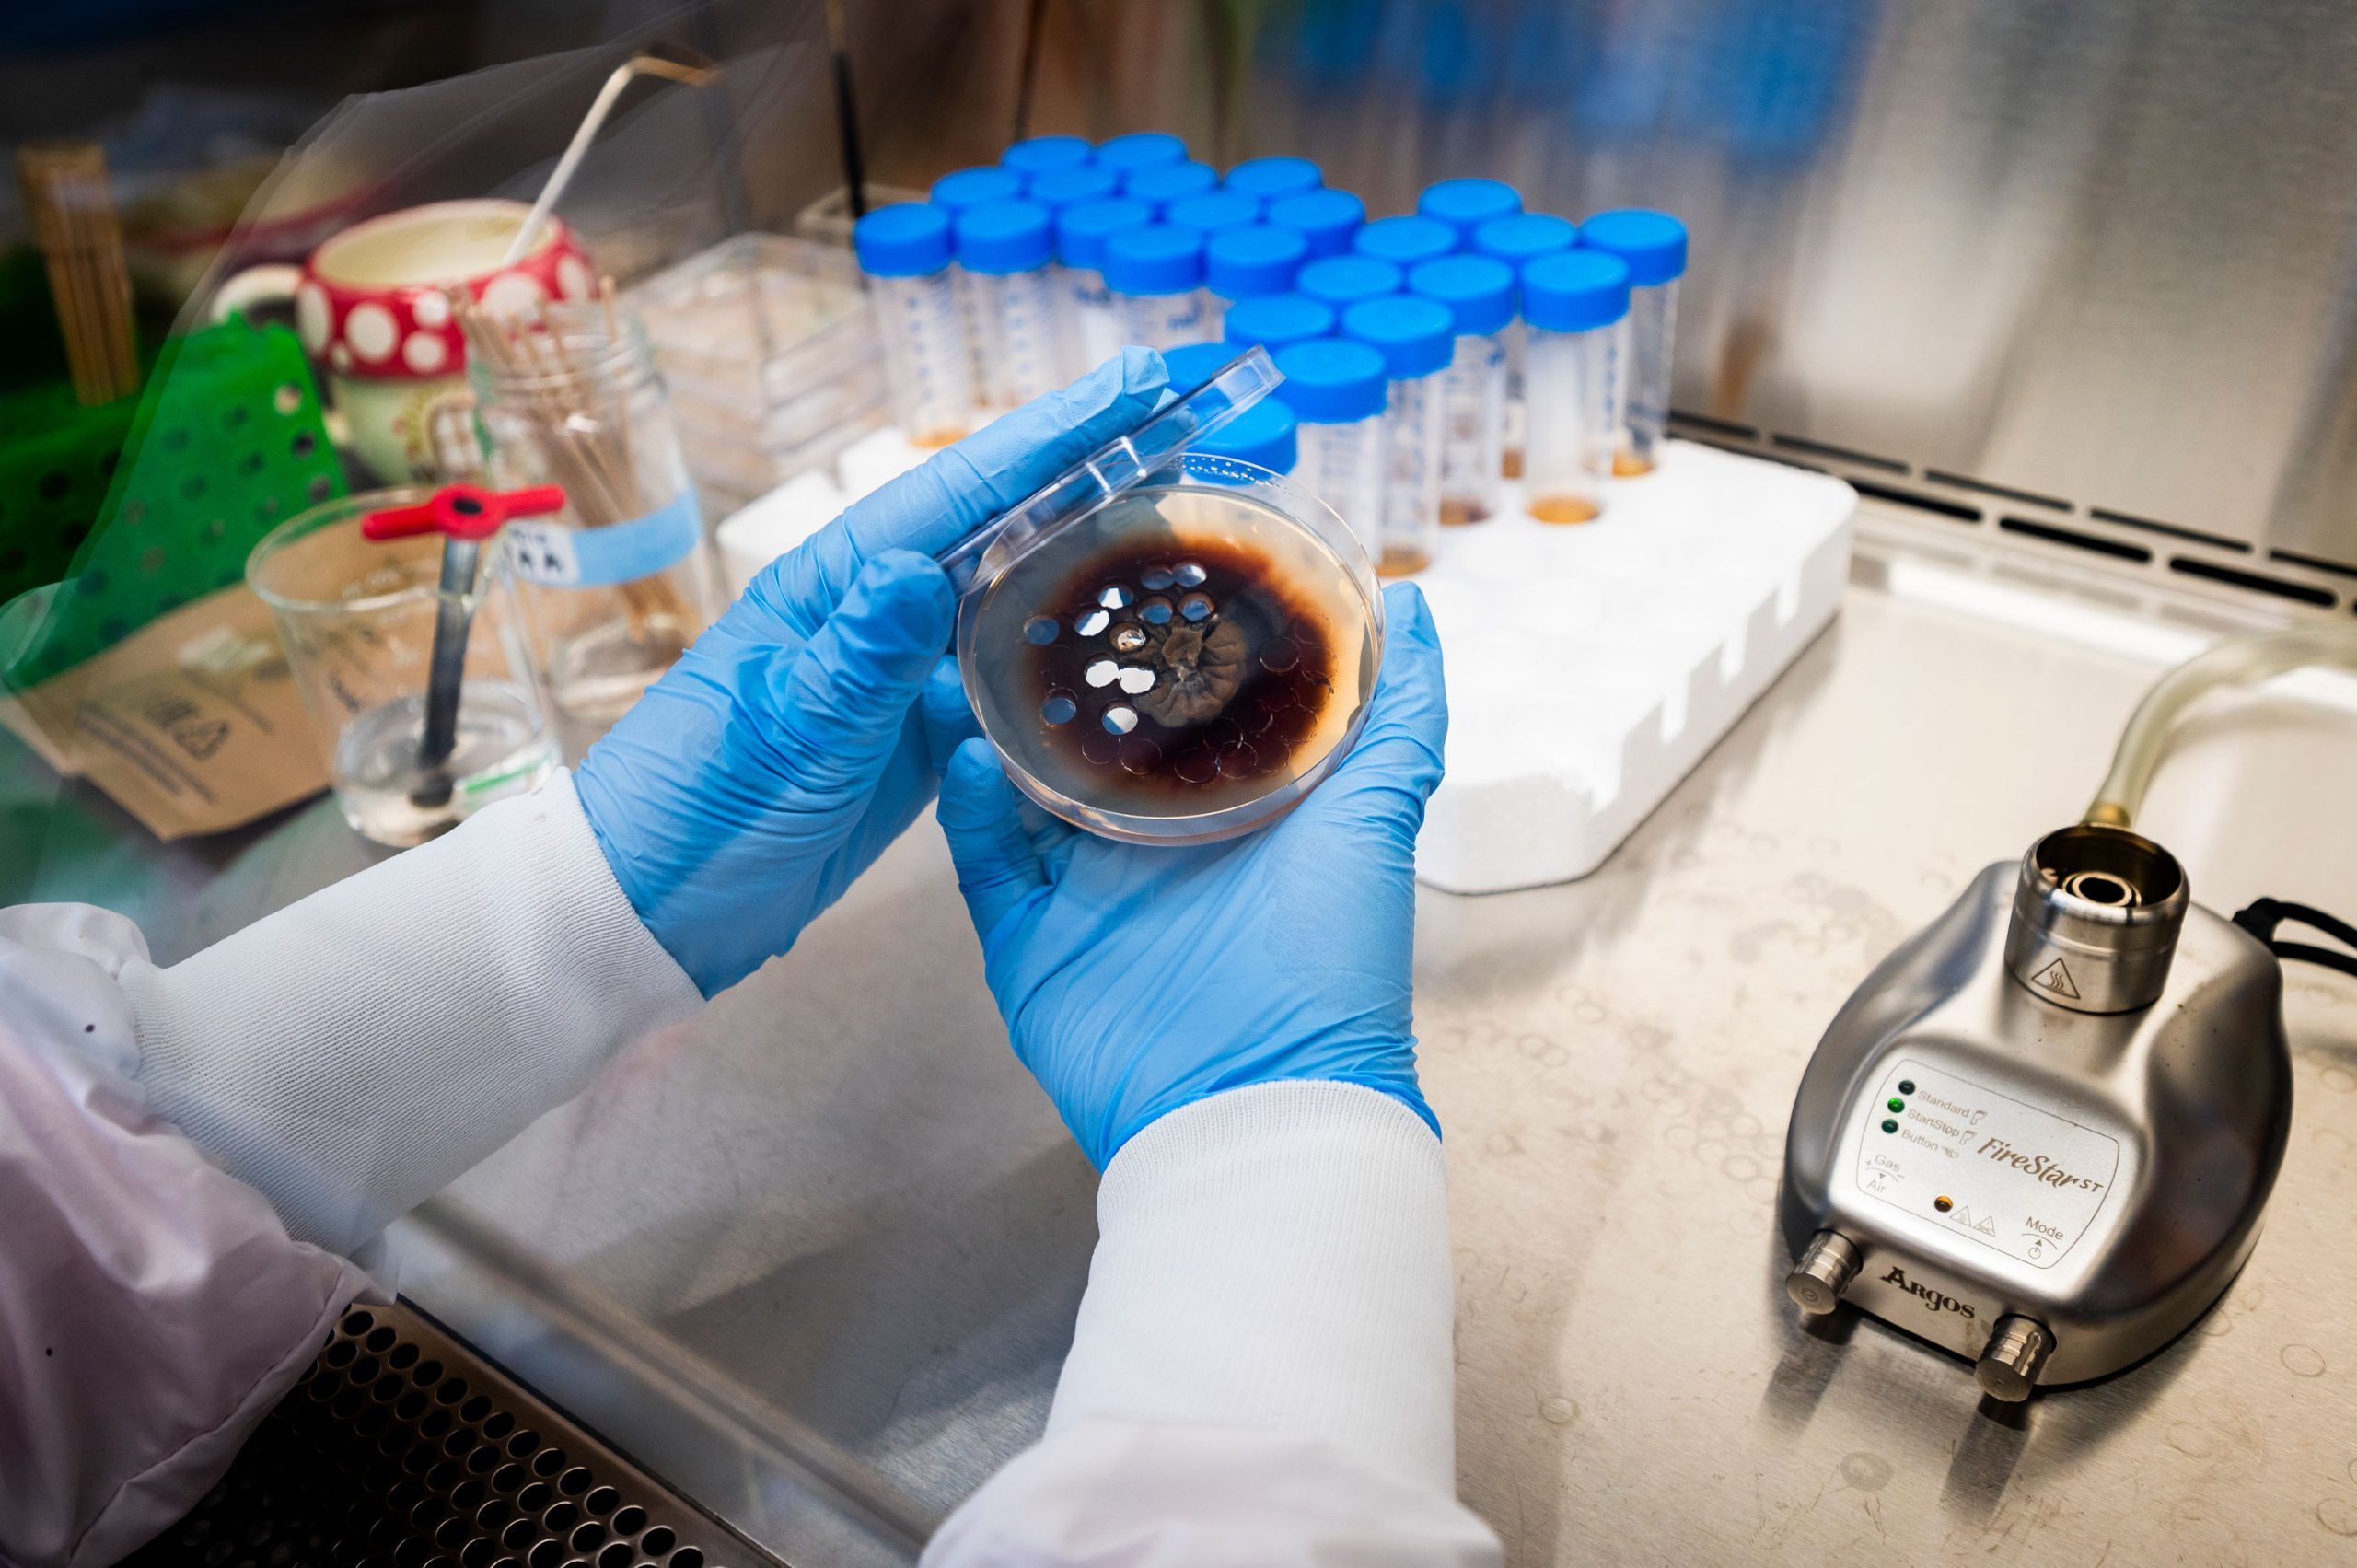
Gloved hands holding an open petri dish with dark fungal growth and white spots inside a laboratory workspace. Background includes a foam rack of capped test tubes and a small metal device labeled “FlowSpar.”

Nature’s Tiny Chemists
Nature’s Tiny Chemists
It’s not often you get a surprise phone call from one of your heroes. But that’s what happened to Dr. Nicholas Oberlies in 1998. Oberlies, now a Sullivan Distinguished Professor of Chemistry at UNCG, was a professionally unfulfilled industrial chemist at the time.
The call was from Dr. Monroe Wall, a scientist at the Research Triangle Institute in North Carolina. Wall and collaborator Dr. Mansukh Wani discovered taxol, a widely used cancer drug, in the bark of the Pacific yew tree. They also isolated camptothecin, found in certain Asian plants, which became another cancer drug.
“They are like superheroes to me,” Oberlies says. “If you talk to an oncologist, they will say that taxol changed the world.”
It’s the kind of work Oberlies had long dreamed of doing. That call brought him to the Research Triangle of North Carolina to work as Wall’s protégé and eventually to UNCG.
Now, Oberlies, assisted by dozens of students and researchers across the state, nation, and globe, is working on potentially world-changing projects. These range from searching for new cancer medicines to discovering how fungi-based chemistry could transform how electricity is generated, transmitted, and stored.
“The big idea in my research group is to understand the chemistry of nature,” Oberlies says. “People have the conception that nature is static – like a tree alone in the woods. But really, nature is sending out and receiving chemical signals all the time.”
Story Highlights
Dr. Nick Oberlies’ lab searches for cancer-fighting compounds in fungi, delves into the chemistry of medicinal herbs, and explores how fungal chemistry could make electricity cheaper and safer.
STORY HIGHLIGHTS
Dr. Nick Oberlies’ lab searches for cancer-fighting compounds in fungi, delves into the chemistry of medicinal herbs, and explores how fungal chemistry could make electricity cheaper and safer.
Unexplored Scientific Territory
Oberlies’ field of natural products chemistry historically focused on plants.
But plants come with challenges. Field expeditions to gather samples are time-consuming and expensive. Getting specimens back to a U.S. lab from other countries can be tricky. And growing plants takes resources – water, soil, greenhouses, and months of time as seeds or cuttings grow big enough for lab analysis.
Oberlies still works with plants. But he’s expanded his work to focus also on fungi – a scientific treasure chest full of novel, undiscovered chemistry that could help protect the environment and treat disease.
“In my lab, we are experts in isolating individual compounds from the mixtures of compounds that a plant or fungus produces,” he says. “Once we have those bioactive substances in a pure form, we carry out a multitude of experiments to figure out how the molecule is put together.”
The opportunities to discover new and potentially useful compounds from fungi are staggering. An estimated 90% of fungal species – millions – are undiscovered.
The Oberlies lab collaborates with Mycosynthetix in Hillsborough, a company that has catalogued over 50,000 species of fungi for use by university and industry scientists. Founder Cedric Pearce is a UNCG adjunct chemistry professor and Coleman Foundation Entrepreneurship Fellow. Oberlies is on the company’s scientific advisory board.
Dr. Huzefa Raja, who has worked in Oberlies’ lab since 2011 and leads the mycology or fungal biology side of the operation, says, “We discover new species all the time.” He estimates they have screened over 10,000 strains on their quest. “We find a new fungus. And it often makes new chemistry.”
Fungi are everywhere in the natural world – in the soil, in fresh and saltwater, in environments of every type. They play a critical role in breaking down organic matter, such as dead wood and leaves, and returning those nutrients to the environment.
“I love mycology because of the diversity of the organisms,” Raja says. “It’s beautiful.”
Raja’s domain is filled with Petri dishes full of fungi. Some were sourced nearby, such as on campus, and some far away, like one from a California beach.
Each species of fungus is an opportunity to discover new compounds with the potential to make life better for people.
Searching for new drugs
Raja and undergraduate researchers April Joseph and Caitlyn Costello work in the Oberlies Research Group mycology lab.
In addition to penicillin, fungi have been the source for cholesterol-reducing statins, antifungal drugs, a medication used to treat multiple sclerosis, and an immunosuppressant that transplant patients sometimes take to ensure their bodies don’t reject a new organ.
About 25% of all drugs are derived from nature; about 60% of anti-infectious disease and anti-cancer drugs come from natural sources.
But, Oberlies says, “There are no anti-cancer drugs derived from fungal metabolites – zero.” Not yet, anyway. In an application for a project funded by the National Cancer Institute that netted the lab $2.7 million in research funds for 15 years, Oberlies wrote, “We strive to change that.”
Drug discovery is hard.
“We discover plenty of things that will kill cancer cells,” Oberlies says. “If you’re a mouse and you’ve got cancer – I’ve got you. But we haven’t gotten beyond that.”
In addition to finding something that successfully attacks cancer in humans, new drugs must overcome three other major barriers: supply, solubility, and patents. “With any natural product, a major problem is supply. This was a huge problem with taxol,” Oberlies says of the yew-based cancer drug. “But, we can grow fungi easily, we can ferment fungi. Penicillin costs pennies because of that.”
The second issue: many natural products don’t dissolve in water. “They just don’t go into saline that you can inject in someone’s arm,” Oberlies says. “But there are techniques to get around that.”
The third issue is patents. To do the research and testing required to take a new compound from just “potentially useful” to “proven to safely and effectively treat disease in humans,” companies invest billions of dollars and years of time. They need patents that allow them to reap the rewards from financially risky drug development research.
But natural compounds can’t be patented. So, they must be altered in some way to make them artificial. “Some of the development process is to make an analogue,” Oberlies explains. “You’ve made the natural product not natural – changed an atom, changed a side chain, to optimize certain properties, and you can suddenly patent it.”
Training Ground
Undergraduates April Joseph and Caitlyn Costello are researchers in the Oberlies lab under Raja’s supervision. “Maintaining all of the fungal strains is almost like having little babies in your lab – you constantly have to keep feeding them,” explains Raja.
“April and Caitlin help the lab do that and help identify new strains by extracting DNA and conducting phylogenetic analyses.” Joseph, a senior this spring, also worked on a project involving one of the unique compounds identified in the Oberlies lab.
Forged solely in places where two fungi – Aspergillus fischeri and Xylaria flabelliformis – compete for dominance, wheldone is the product of fungal chemical warfare.
In collaboration with a pharmacology lab at the University of Illinois Chicago led by Dr. Joanna Burdette, the researchers have found that wheldone displays cytotoxic activity against breast, melanoma, and ovarian cancer cells in vitro.
“I’m working on producing the compound at a larger scale,” explains Joseph. The materials will be sent to their collaborators in Chicago for testing in mice. “Research has given me the chance to think critically and contribute to something bigger than myself. It’s an experience that has truly shaped my future.”
The Oberlies lab has mentored nine postdocs, 22 graduate students, and scores of undergraduates.
“This is what the beginning stages of developing a fungal drug to treat cancer looks like,” says Raja. “We offer a very strong training ground for our undergraduate researchers, with many going on to prestigious graduate programs, professional schools, and the workforce.”
Herbal supplements under the scope
From supplement stores to gas stations, many herbal products are sold with the implication they can improve your health or address illness. There’s often little scientific backing for those claims.
Before scientists can assess whether an herbal remedy is effective, they must know what’s actually in it. That’s where Oberlies and Dr. Nadja Cech, a UNCG natural products chemistry professor, come in.
“Herbal remedies are a mixture. Sometimes they’re a mixture of five or six compounds, sometimes they’re a mixture of dozens of compounds,” Oberlies says. “If you’re going to study Herb X, I want to make sure that you actually know what the herb is.”
For the last decade, Oberlies and Cech have analyzed popular herbal products, including green tea, milk thistle, cinnamon, CBD, and kratom.
Kratom, for example, has been used in Southeast Asia, where the tree grows natively, since at least the 19th century to treat pain and other ailments.
Dr. Mary Paine, a pharmaceutics professor at Washington State University, worked with Oberlies and Cech to prepare for the only U.S. clinical trial of kratom. One finding of that study was that kratom might increase the overdose risk among opioid users.
Energy for the Environment
The latest initiative that has grown out of Oberlies’ lab started with a chance question by another professor in a departmental meeting.
A few years ago, Oberlies’ doctoral student Zeinab Al Subeh made a presentation to the faculty – a part of the graduate student training process in the Department of Chemistry and Biochemistry. They nurture rich scientific discussions that can blossom into new discoveries.
Dr. Shabnam Hematian asked the student about the “redox potential” of the fungal-derived compounds she was studying. Al Subeh didn’t know the answer – it relates to how efficiently the compound moves electrons around. However, she took the opportunity to explore the subject with one of Hematian’s electrochemistry-focused graduate students.
That started a collaboration to explore the potential of fungal chemistry in applications related to the generation, storage, and transmission of electricity. The collaboration has now bloomed into a rich, cross-university, cross-disciplinary research initiative called NICER – Nature Inspired Collaborative Energy Research.
The highly collaborative effort was kickstarted by a $1.5 million Research Opportunities Initiative – ROI – grant from the N.C. General Assembly. It’s now led by Oberlies and UNCG’s Dr. Minjeong Kim, assistant professor and associate head of computer science.
Graduate Energy
Growing fungi in a Petri dish is one thing. Deciphering their unique chemistry, identifying useful substances and figuring out how to increase production of them is entirely different – that’s doctoral student Reema Al-Qiam’s job.
She’s focused on a class of fungal-produced compounds called perylenequinones that could have energy applications.
Since starting at Oberlies’ lab, she’s figured out how to ramp up production a thousand-fold – from a few milligrams to multiple grams that can be supplied to other researchers.
In addition to simplifying the process, the Jordanian student has discovered how to use more environmentally friendly chemicals to produce the perylenequinones.
Now, she’s focused on making changes to the molecule that affect its characteristics and behavior in different conditions, such as when it’s exposed to light of different colors. “I take the compounds from nature and try to improve the structures,” she says. “Right now, I’m adding something that increases light absorption.”
The Next Generation
Penicillin changed the world. It and subsequent antibiotics remade medicine – extending average human lifespans by decades and turning once-deadly infections into, in many cases, mere medical annoyances.
“All of that started with a scientist making an observation in his lab. It was then picked up by chemists who isolated the molecule and figured out its structure. Then, teams of scientists developed ways to supply it at scale,” Oberlies says.
“A single observation, in a single Petri dish, followed to completion creates an antibiotics revolution.” That’s why he considers his work with students his most important contribution. “If we don’t train the next generation of scientists, who will do those kinds of experiments for the next 100 years?”
Learn more about Dr. Nick Oberlies in our Senior Research Excellence Award Winner interview